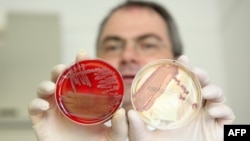
Ученый-медик в исследовательскими чашками Петри. Иллюстративное фото.

Радио Азадлыг
Успехи и неудачи всемирного здравоохранения в 2013
БОРЬБА С ВИЧ/СПИДом
В 2013 году были сделаны новые шаги в борьбе против ВИЧ и СПИДа. Ученые из Квинслендского института медицинских исследований объявили в январе об открытии способа модификации протеина ВИЧ для защиты от обычных инфекций.
Адъюнкт-профессор Дэвид Харрич сказал, что если клинические тесты будут успешными, то это может стать эффективным способом борьбы со СПИДом. По словам Дэвида Харрича, «если и не является лекарством от ВИЧ, то имеет потенциал прекратить болезнь», поскольку помогает пациентам поддерживать здоровую иммунную систему и бороться с обычными инфекциями.
Еще одним возможным достижением стало объявление в марте, что ребенок, рожденный с ВИЧ, как кажется, вылечился после очень раннего лечения обычными лекарствами. Всё еще необходимо провести дополнительные тесты, чтобы узнать, может ли лечение иметь то же действие на других детей, но ребенок в Миссисипи не имеет никаких признаков инфекции после приблизительно года лечения.
РОСТ ПОЛИОМИЕЛИТА
Вспышки полиомиелита в Пакистане и Сирии поставили под угрозу усилия по искоренению этой чрезвычайно инфекционной болезни.
В Пакистане — одной из трех стран, где полиомиелит является эндемическим, — оппозиция в лице исламистских боевиков помешала усилиям по выработке иммунитета у детей, в некоторых случаях похищая или убивая команды по проведению прививок.
В результате количество зарегистрированных случаев болезни увеличилось с 58 в 2012 году до 70 на сегодняшний день 2013 года. Было зарегистрировано 50 случаев в Нигерии и девять в Афганистане, соответственно по сравнению с 110 и 31 в прошлом году.
В ноябре Всемирная организация здравоохранения (ВОЗ) связала вспышку полиомиелита в Сирии, парализовавшую 13 детей, с передачей вируса из Пакистана. Полиомиелит в Сирии был полностью уничтожен 14 лет назад, но за годы гражданской войны программы прививок сократились.
НОВЫЕ ВИРУСЫ
Эксперты в сфере мирового здравоохранения обеспокоены появлением нового смертельного вируса, обнаруженного в 2012 году. Так называемый коронавирус может вызвать симптомы, похожие на симптомы острой пневмонии и повреждения почек и других органов. Он похож на SARS, убивший около 800 человек в мировой эпидемии в 2013 году.
Пока зарегистрировано только 160 случаев болезни на Ближнем Востоке и в Европе, но процент смертности остается чрезвычайно высоким — 68 смертельных случаев до сегодняшнего дня. Вирус может передаваться от человека к человеку, что помогает ему быстро распространяться.
Эксперт по эндемическим заболеваниям в ВОЗ Грегорий Хартл пояснил, что вирус относится к той же семье, что и вирус обычной простуды и SARS, однако немного отличается от них.
Боязнь коронавируса совпала с сообщениями о появлении нового смертельного вируса в Китае. С февраля было зарегистрировано 140 случаев H7N9 и 45 смертей. Однако пока нет доказательств, что этот птичий вирус может передаваться от человека к человеку.
КОНТРОЛЬ ИСКУССТВЕННЫХ КОНЕЧНОСТЕЙ МОЗГОМ
В США подразделение военного исследования DARPA летом опубликовало видео, в котором бывший старший сержант Глен Лехман, потерявший правую руку во время службы в Иране, использует искусственную руку, чтобы поднести ко рту кружку кофе, накинуть шарф и поднять теннисный мяч.
Его протез базируется на методе Targeted Muscle Re-innervation, позволяющем руке двигаться посредством активации нервов, ранее передававших моторные сигналы от мозга к отсутствующей конечности, и соединения этих нервов с другим, расположенным рядом с большим мускулом, таким как бицепс или грудные мышцы.
БОЛЕУТОЛИТЕЛИ В УКРАИНЕ
Заслуживает внимания новое законодательство, принятое в мае Украиной для облегчения доступа смертельно больных пациентов к болеутоляющим лекарствам, таким как морфий.
Украина стала первым государством среди стран — членов СНГ, упростившим выписку рецептов и выдачу сильных болеутоляющих средств, которые могут облегчить ненужные страдания.
Диедерик Лохман — старший исследователь по здравоохранению в Human Rights Watch — назвал эту меру победой смертельно больных пациентов, которых раньше ожидала перспектива медленной и болезненной смерти дома.
Радио Азаттык
Bütün xəbərləri izləyin
Как украинские "беркутовцы" с Майдана стали ОМОНом с Тверской
Во время антикоррупционной акции на Тверской в Москве среди ОМОНа был замечен Сергей Кусюк, бывший заместитель командующего киевского "Беркута" – бойцы этого подразделения, непосредственно под командованием Кусюка, избивали и задерживали участников Майдана. Теперь он служит в российской Нацгвардии
Первый канал с реальной картинкой
12 июня Первый канал показал репортаж из центра Москвы. В него вошло не все. Радио Свобода восстановило то, что осталось за кадром.
Имидж – все. Почему азербайджанские правозащитники и независимые журналисты попадают в тюрьму
На похищенного в Тбилиси азербайджанского журналиста-расследователя Афгана Мухтарлы на родине завели уголовное дело. Почему и за что критики азербайджанской власти оказываются в тюрьме – разбор НВ
Настоящее Время. 3 мая
О чем президенты Турции и России договорились в Сочи? Вступил в силу приговор оппозиционеру Навальному: это может помешать ему принять участие в выборах президента РФ. История успеха в самом депрессивном регионе Латвии. В России дети сами организовали переправу через реку, чтобы добраться до школы
Домик у океана. Как выглядит вилла для Людмилы Путиной – репортаж с юга Франции
На юге Франции нашли особняк бывшей жены президента России Людмилы Путиной. Виллу по соседству с дочкой – Катериной Тихоновой – приобрел новый муж Путиной – Артур Очеретный. Сперва Очеретные не хотели раскрывать информацию о себе. Но по закону, застройщик обязан предоставить данные о заказчике.
Настоящее Время. 27 апреля
Избрана новая мера пресечения отстраненному от должности главе Фискальной службы. Поставку электроэнергии в т.н. "ЛНР" могут оплатить российские потребители. Снос пятиэтажек в Москве: чем закончится спор городских властей и жильцов? Михаил Барышников стал гражданином Латвии
Настоящее Время. 20 апреля
Мать фигуранта дела о теракте в Петербурге назвала съемку ФСБ о его задержании с оружием постановочной. Кто на самом деле разработал план вмешательства России в выборы президента США, и был ли такой план? Кандидат в президенты Франции Фийон настаивает, что "Крым - исторически российская территория"
Страна самых высокопоставленных телеведущих. Почему политики захватили телеэфир Украины
Украинские политики хотят не только приходить в гости на телевидение, но и сами выступать в качестве ведуших. Рассказываем, кто из политиков стал телеведущим в Украине
Настоящее Время. 19 апреля
Международный суд в Гааге вынес решение о предупредительных мерах по отношению к Москве - не в пользу Украины. В Чёрном море раскололся надвое и затонул сухогруз. В редакцию Новой газеты после статьи о геях в Чечне пришло письмо из Грозного с "белым порошком", а ЛГБТ-активисты подали на газету в суд
Настоящее Время. 18 апреля
Обострение в отношениях Тбилиси и Москвы: глава МИД РФ Лавров приехал в непризнанную Абхазию открывать посольство. Протесты в Стамбуле: оппозиция требует отменить результаты референдума. В аннексированном Крыму возобновился суд по делу журналиста Николая Семены, обвиняемого в угрозе целостности РФ
Настоящее Время. 12 апреля
Госсекретарь США Рекс Тиллерсон в Москве встретился с Путиным и Лавровым. Бомбы на пути футболистов: кто устроил взрывы в немецком Дортмунде? 30 вооруженных людей в штатском переходят границу Беларуси и Литвы и объявляют самопровозглашенную республику. Остался месяц до финала Евровидения в Киеве
Погром в темноте: в Бишкеке под покровом ночи неизвестные на тракторе снесли три десятка частных домов
В районе частной застройки Ново-Павловка недалеко от Бишкека неизвестные ночью снесли три десятка недостроенных домов. Владельцы обвиняют в погроме бывших владельцев участков, которые когда-то продали землю новым жильцам. А местные власти говорят, что в Ново-Павловке вообще запрещено строительство
Настоящее Время. 11 апреля
Рекс Тиллерсон прилетел в Москву: есть ли у него способ заставить Кремль отказаться от поддержки Асада? Прошло 6 лет после теракта в минском метро, вопросы до сих пор остались. Более 1000 человек были казнены за год в мире: доклад Amnesty International. В Москве прощаются с поэтом Евгением Евтушенко
Как живет город, который его жители никогда не видели. Неизвестная Россия
Русиново Калужской области – словно Россия в миниатюре. Со всеми ее проблемами и заботами. Только вот обитатели его находятся совсем в другом мире. Там, где не просто "трудно жить", а откуда выбраться уже невозможно. Там, где нет солнечного света и лиц родных людей
"Наш дурдом голосует за Путина": в Казани прошел арт-пикет "Открытой России"
8 апреля в Казани региональное отделение "Открытой России" провело арт-пикет, на котором его участники в ироничной форме выступили против политики президента Владимира Путина.






















